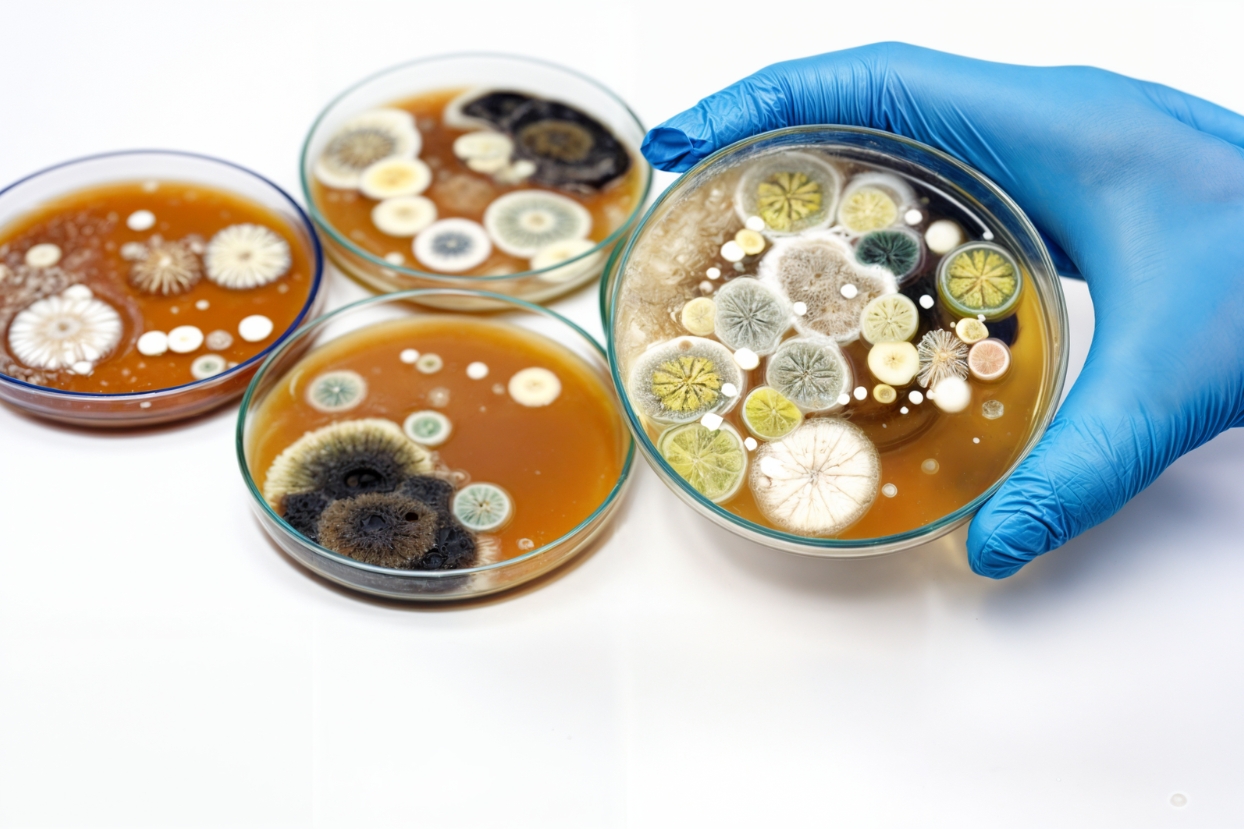

Análisis de Alimentos, Bebidas y Suplementos Alimenticios
En nuestro laboratorio aseguramos la calidad de tus productos con nuestros servicios de análisis de alimentos, bebidas y suplementos alimenticios. En nuestro laboratorio te ofrecemos resultados rápidos, confiables y 100% alineados con la normativa vigente, para que puedas garantizar la seguridad y confianza que tus consumidores esperan. Trabajamos con tecnología avanzada y un equipo experto, para que tu marca se destaque por su compromiso con la calidad.
Control y Análisis
Estabilidad y Seguridad
Realizamos análisis fisicoquímicos y microbiológicos, tanto iniciales como de estabilidad, para determinar con precisión el periodo de vida útil de una amplia gama de productos: alimentos, suplementos alimenticios, productos farmacéuticos, veterinarios, bebidas alcohólicas, entre otros.
Nuestro laboratorio está equipado con tecnología de última generación para llevar a cabo estudios de estabilidad acelerada y en tiempo real, garantizando resultados confiables y alineados con las normativas vigentes.